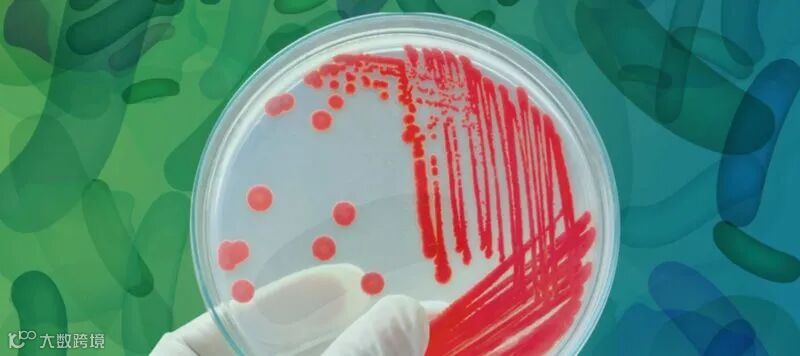

大多数生命科学研究涉及培养和检测微生物,特别是细菌。在培养这些微生物样品时,实验室通常需要挑选一个特定的菌落并进行复制。那么什么是菌落,为什么它在生物学研究中如此重要?菌落是由单个母细胞培养而来的大量细菌,通常在固体琼脂培养基上生长。
通过培养单细胞细菌菌落,研究人员可获得可靠、纯净的材料,用于测试或生产蛋白质。
菌落形态
描述细菌群体的特征在任何研究中都很重要,因为它有助于细菌的鉴定,更有利于选择出合适的克隆菌落,在流程的下一阶段使用。
为此目的培养菌落通常需要在培养板上散布细菌样本。然后按照菌落挑选程序来鉴定细菌,这就需要你熟悉细菌菌落形态。当在琼脂培养基上生长时,不同种类的细菌可以呈现不同的物理特性,如下所述:
形态——从顶部观察时菌落的基本形状,包括圆形、不规则、丝状和类根。
立面图——从侧面观察时菌落的横截面形状。包括凸起、平坦、凸起、伞形、火山口状和枕状隆起。
边缘——放大后菌落边缘的形状。常见的例子包括全缘(光滑)、波状(波浪状)、蚀状(锯齿状)、丝状、叶状和卷曲。
表面——菌落表面的外观。例如光滑、粗糙、发亮、无光泽、有皱纹、粘液状、粘性等。
不透明度——细菌菌落的不透明度,例如不透明、透明、半透明和彩虹色。
颜色——菌落的颜色,可以是白色、红色、紫色等。
菌落在生命科学中的应用
培养细菌样本和选择特定的菌落在许多应用中都非常常见,包括微生物组学研究、生物燃料研究等。由于研究实验室需要高通量和高精度,许多实验室在处理样本时会使用诸如菌落挑选仪和自动液体处理机之类的工具。
菌落培养和挑选通常是复杂而广泛的工作流程的一部分,因此生长和复制正确的细菌菌落至关重要。培养出来的菌落通常用于菌落PCR、蛋白质纯化、质谱分析、酶分析和其他各种分析检测。
克隆菌落的自动化处理
像许多实验室研究方面一样,细菌菌落的生长和挑选可以通过机器人技术和自动化软件实现自动化。
事实上,实验室可以在整个工作流程中实现自动化,从准备细菌样本进行涂板培养,到从挑选的菌落中分离目标的分子或蛋白质。
克隆菌落挑选仪通过先进的成像硬件和算法,能够准确地选择所需要的菌落。它可以根据菌落大小确定菌落中的平均细胞数,根据可定义的参数(如半径、颜色或间隔)自动识别所需的菌落,并选择符合预设参数的菌落。它还可以自动记录和存储选定克隆菌落的信息,确保数据完整的档案记录。
处理细菌菌落是任何生物实验室的重要组成部分,因为它们通常用于研究和生产蛋白质和酶。因此,准确地识别菌落形态并选择合适的菌落可以显著提高你的实验结果。
想知道你的实验室适合什么样的菌落挑选仪?欢迎来咨询伯齐科技。
推荐阅读:
>>Hudson Robotics:增加流式细胞仪COVID-19检测通量
>>Hudson Robotics:自动化COVID-19研究的核酸/蛋白提取纯化
>>Hudson Robotics:增加流式细胞仪COVID-19检测通量
>>挑菌原来可以这样简单方便!
>>Rapid_pH 自动pH检测仪——带温度补偿的pH计
>>小身材高通量菌落挑选仪,自动化so easy!
>>Hudson生物合成自动化方案
>>新品推荐:Hudson PlateCrane SciClops机械臂
>>高通量自动化pH定量新方案
>>新品推荐:Rapid_pH™ pH值自动测定仪
>>重磅推荐:Hudson RapidPick自动克隆菌落挑选仪
欢迎关注伯齐官方微信(微信公众号:Bio-Gene)
回复:hudson,查看相关视频
长按以下二维码可识别关注公众号

伯齐科技有限公司
Bio-Gene Technology Ltd.
广州伯齐生物科技有限公司
热线:176 2009 3784
www.bio-gene.com.cn
marketing@bio-gene.com.cn

